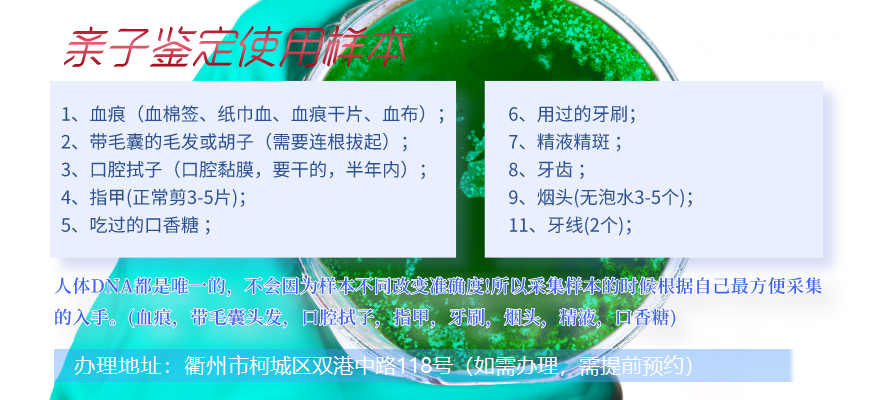

衢州柯城親子鑒定一直是一個飽受爭議討論的話題,不過它也有一些非常好用的運用。例如,有一些父母需要確定自己的兒子是否存在遺傳病史,那樣開展親子鑒定就可以獲得確立的回答。除此之外,一些醫學臨床研究也要開展親子鑒定,來確認一些遺傳病基因由來。
盡管親子鑒定的使用范圍廣泛,但是我們不可忽視它其背后的情感糾葛。很多人都認為,親子鑒定會在婚姻破裂的情形下應用,但實際上,外遇僅僅是一種概率。有些夫妻會因懷孕前后的身體變化和產生質疑,這時候開展親子鑒定能夠幫助她們處理顧慮,減少不必要的爭執和猜忌。
不論什么時候開展親子鑒定,我們都要維持客觀心態,尊重客觀事實,重視別人的感受。成為家庭的重要前提,真情的必要性是難以被取代的。因而,我們應該盡一切努力守護好家庭幸福,讓家庭成為一個幸福快樂的港灣。
衢州柯城懷孕期間去哪里做親子鑒定?
如果你需要在衢州柯城辦理孕期無創親子鑒定,可在線咨詢衢州柯城萬核親子鑒定服務機構。孕期親子鑒定只需采集準媽媽10ml外周血,疑似父親可以采集血液樣本,或者是血痕、精液、精斑、帶毛囊的頭發、指甲、唾液、口香糖、口腔拭子、礦泉水瓶、牙線、煙頭等(任選其一即可)等生物材料,測試它們之間的DNA信息是否匹配。這種測試可以確定一個孩子是否為某個人的親生子女,或者確定兩個人是否具有親緣關系。
通常,當您想要進行孕期無創親子鑒定時,與衢州柯城萬核基因聯系:電話:4001789498,討論樣本采集方式,測試步驟和費用等相關問題,辦理地址:衢州市柯城區雙港中路118號(如需辦理,需提前預約)。
衢州柯城無創產前親子鑒定多久出結果
無創產前親子鑒定的結果需要的時間因實驗室的工作流程、鑒定樣本的種類、復雜性以及所涉及的親屬關系而異。一般情況下,衢州柯城萬核親子鑒定服務機構對于血液樣本的鑒定結果需要5-7個工作日,而口腔拭子或者其他非血液樣本的鑒定結果可能需要更長的時間。
但是,有些委托人要求加急,所以衢州柯城萬核基因可提供加急鑒定服務,可以在較短時間內出具結果,但需要額外支付費用。
需要注意的是,樣本品質和數量可能會影響鑒定的準確性和時間。如果提交的樣本不夠好,甚至無法提取到足夠的DNA,則需要重新提取樣本,這樣可能會延長鑒定的時間。因此,在提交樣本時需要確保樣本的足夠質量和數量,以盡快獲得鑒定結果。
總的來說,無創產前親子鑒定的時間可能會在5-7個工作日之間,而加急服務可能會縮短到一天到三周的時間。值得注意的是,在鑒定結果出具前,衢州柯城萬核心和實驗室都會積極保護鑒定數據的安全和保密性。
衢州柯城胎兒親子鑒定流程:
1,委托人可事先與衢州柯城萬核親子鑒定咨詢中心工作人員聯系,客服工作人員會在第一時間幫您解決疑問,并幫您獲取鑒定專家的預約。
2,被鑒定者需親自到鑒定中心現場驗證身份,胎兒親子鑒定樣本采集。
3,樣本送入實驗室進行檢測。
4,鑒定報告一般在5-7個工作日出具,同時提供加急服務,屬于付費加急,不同加急時間費用是不一樣的,無創一般為15個工作日出結果。
胎兒親子鑒定樣本采集方法:
1,羊水樣本采集:通常在孕期第15周后進行,婦產科醫生在B超的監測下從產婦的腹壁內抽出少量的羊水做為樣本。
2,絨毛樣本采集:通常在懷孕第10周-13周進行,抽出絨毛膜細胞組織(最終形成胎盤)的一小部分作為化驗的樣本。
3,靜脈血采集:抽取靜脈血相對簡單,孕婦懷孕5周以上,保證衛生的前提下用抗凝管抽取孕婦手臂靜脈血10ml左右。(這種技術具有非侵入性、安全、準確等優點,適用于需要進行親子鑒定的家庭。)
無創胎兒親子鑒定可采集什么樣本?
無創胎兒親子鑒定取樣安全性便捷,孕媽媽采集10ml靜脈血,抽血不需要空著肚子,正常吃飯就可以抽血化驗。疑父采集血夜、血漬、帶毛囊的頭發、手指甲、口腔拭子、軟毛牙刷、煙蒂等(隨意選擇其一)。
衢州柯城孕婦靜脈血親子鑒定多久可以做
親子鑒定是現代社會不可缺少的一項服務,它可以幫助解決很多家庭中的親子關系問題,比如孩子的生父是誰,是否存在血緣關系等等。對于那些需要進行親子鑒定的家庭來說,早做親子鑒定對雙方和孩子帶來的傷害也必將越小。
很多人會認為親子鑒定只有在親子關系出現問題時才需要進行,其實并非如此。比如,孕期親子鑒定就是一種非常好的方式,可以讓孕媽媽和未出生的寶寶在最短的時間內確認親子關系,避免不必要的猜測和猜忌。而無創胎兒親子鑒定更是一種非常便捷和安全的方式,不需要入侵式的采樣,對孕婦和胎兒的健康沒有任何影響。
孕期親子鑒定的實施也非常簡單,孕5周到寶寶出生前,只需要采集孕婦外周血,利用新一代DNA測序技術對母體外周血漿中的游離DNA片段進行測序、生物信息分析,從中得到胎兒的遺傳信息來確認親子關系。整個過程只需要5-7個工作日,非常快捷和準確。
對于那些已經決定做孕期親子鑒定的家庭來說,如果還存在一些疑慮和困惑,可以通過在線咨詢等方式衢州柯城萬核親子鑒定咨詢中心,向工作人員尋求幫助和支持。讓我們一起為孕媽媽和未來寶寶的健康和幸福保駕護航!



江山上戶口親子鑒定是一種基于DNA技術的親子鑒定方法,它是一種有...[詳細]

隨著社會的發展和科技的發展,市場上有很多親子鑒定機構,親子鑒定分...[詳細]

個人隱私親子鑒定的主要特點在于確保你的隱私安全和你的親子關系的可...[詳細]

個人鑒定適用于只想了解親子鑒定結果,而并不打算把鑒定結果作為證據...[詳細]

在衢州做親子鑒定可以去司法鑒定中心,衢州的親子鑒定正規機構有三類...[詳細]

常山孕期胎兒親子鑒定是一種科學方法,能通過DNA檢驗來決定親子關...[詳細]

開化上戶口親子鑒定是指在法律范圍內進行的親子關系確定,其結果具有...[詳細]

在過去,衢州親子鑒定只能依靠生完孩子收集嬰兒的血液樣本去進行,此...[詳細]

相對于條件苛刻的司法鑒定,個人隱私親子鑒定具有保密、簡單易行、避...[詳細]

親子鑒定可分為個人親子鑒定和司法親子鑒定。不同鑒定有不同用途,費...[詳細]

衢州柯城正規親子鑒定中心電話地址...[詳細]

衢州衢江正規親子鑒定中心電話地址...[詳細]

常山個人親子鑒定機構在哪...[詳細]

龍游正規親子鑒定機構地址查詢...[詳細]

常山親子鑒定中心電話地址...[詳細]

龍游個人親子鑒定機構那里有...[詳細]

衢州親子鑒定中心地址查詢...[詳細]

衢州衢江哪里有個人親子鑒定機構...[詳細]

衢州柯城個人親子鑒定機構那里有...[詳細]

開化個人隱私親子鑒定機構...[詳細]
推薦檢測中心